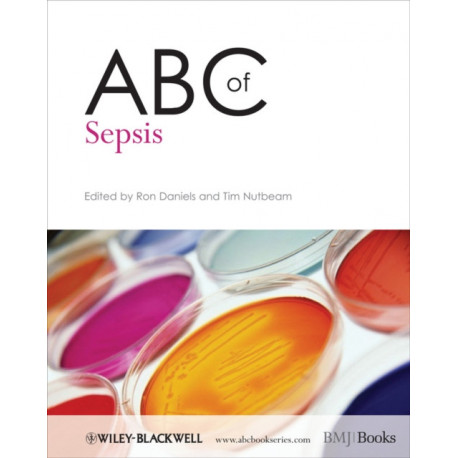
ABC of Sepsis

Kurv
Vare
varer
(tom)
Ingen varer
Fastlægges senere
Forsendelse
0,- kr
I alt
ABC of Sepsis
(Bog, Paperback / softback, Engelsk)
Forlag:
John Wiley and Sons Ltd
- Type: Bog
- Format: Paperback / softback
-
Sprog:
Engelsk

- ISBN-13: 9781405181945
- Se flere detaljer ▼
Bemærk: Kan ikke leveres før jul.
Beskrivelse
The importance of early prevention and treatment of sepsis has never been greater. In the UK alone sepsis contributes to more deaths than lung cancer, from bowel cancer and breast cancer combined, and approximately one third of patients who suffer from severe sepsis die.
Læsernes anmeldelser (0)
Alle detaljer
| Forlag | John Wiley and Sons Ltd |
| Forfatter | R Daniels |
| Type | Bog |
| Format | Paperback / softback |
| Sprog | Engelsk |
| Udgivelsesdato | 04-12-2009 |
| Første udgivelsesår | 2009 |
| Serie | ABC Series |
| Fagredaktør | Ron (Good Hope Hospital Daniels, Tim (Emergency Medicine Specialist Trainee Nutbeam |
| Originalsprog | United Kingdom |
| Sideantal | 112 |
| Indbinding | Paperback / softback |
| Forlag | John Wiley and Sons Ltd |
| Sideoplysninger | 112 pages |
| Mål | 273 x 220 x 6 |
| ISBN-13 / EAN-13 | 9781405181945 |

